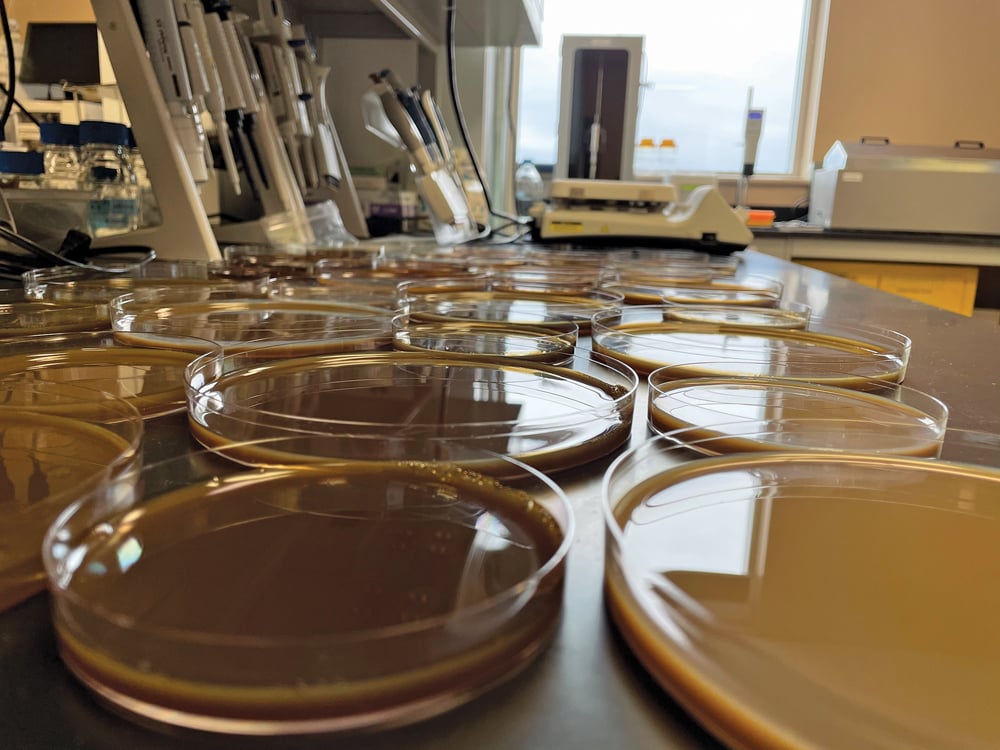
Solvent casing is used to form canola protein into a plastic-like film.

Manitoba Co-operator: Creating a canola-based plastic alternative
New research turns canola protein into strong, flexible films meant for food packaging
July 19, 2023 —
Canola growers may one day be able to add food packaging to their list of markets.
New research at the University of Manitoba draws on canola meal protein as a feedstock for biodegradable food product packaging.
“I think it’s a more sustainable solution to the challenges created by all the petroleum-based plastic food packaging materials,” said Thilini Dissanayake, the PhD student whose master’s thesis inspired the project.






